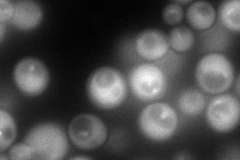
YDR486C
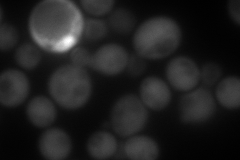
YDR486C
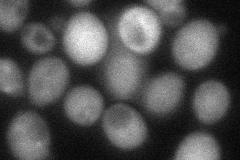
YDR486C

View description
Cytoplasmic and vacuolar membrane protein involved in late endosome to vacuole transport; required for normal filament maturation during pseudohyphal growth; may function in targeting cargo proteins for degradation; interacts with Vta1p
Localization:
Intensity:
Fold change:
Significance:
-
C’ GFP library in SD

vacuole membrane34.32 -
N' NOP1pr-GFP in SD
cytosol,punctate176.746 -
N' TEF2pr-mCherry in SD
cytosol267.237 -
N' NATIVEpr-GFP in SD

punctate53.5609 -
N' TEF2pr-VC and Cyto-VN in SD
cytosol61.4355 -
C’ GFP library in SD+DTT

vacuole membrane44.351.29No -
C’ GFP library in SD+H2O2

vacuole membrane40.081.16No -
C’ GFP library in Starvation Media

vacuole membrane37.561.09No -
C’ GFP library on the background of Pup2-DaMP

vacuole membrane -
C’ GFP library on the background of CCT mutant

vacuole membrane32.73850.953668No
